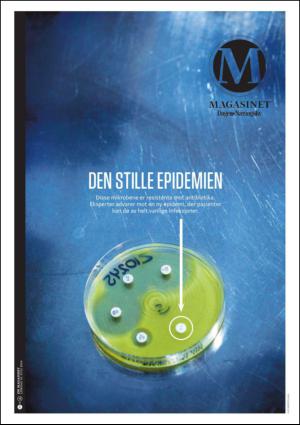

Dagens Næringsliv Magasinet 7/19/14
Dagens Næringsliv Magasinet 7/19/14 is an edition of the publication Dagens Næringsliv Magasinet. The edition contains 40 pages that you can see below. The edition is a supplement to Dagens Næringsliv 19.07.14. The PDF file of the edition is 8.90 MB. The previous edition of this publication is Dagens Næringsliv Magasinet 12.07.14. The next edition of this publication is Dagens Næringsliv Magasinet 26.07.14. Click on the publication's link Dagens Næringsliv Magasinet to see information about other editions.
The publication Dagens Næringsliv Magasinet is a newspaper and are published by the publisher Dagens Næringsliv. The first and last edition of this publication in the archive is Dagens Næringsliv Magasinet 19.01.13 respectively Dagens Næringsliv Magasinet 18.02.17.
The archive of Dagens Næringsliv contain 6558 editions which represents 351202 pages. All the editions are indexed in our searchable archive. Dagens Næringsliv Magasinet is a supplement to the main section Dagens Næringsliv.

 English
English Norwegian
Norwegian Swedish
Swedish





































